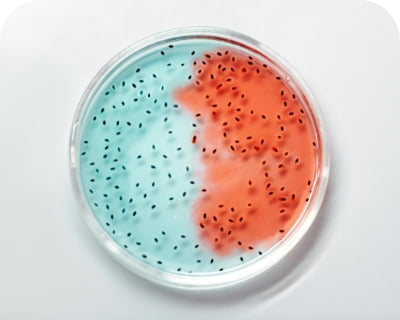

등록된 상품이 없습니다.
ABOUT FINE SCIENCE-Bio
Fine Science Introduction

화인사이언스는 신뢰, 정직, 창의 세 가지 핵심가치를 추구하며
끊임없는 도전과 혁신으로 고객과 함께 일하며 성장하는 기업으로 나아가겠습니다.
언제나 변함없이 좋은 품질의 제품을 정직한 가격으로 제공하겠습니다.

신 뢰
화인사이언스는 신뢰와 정직 , 협력 그리고 창의를 바탕으로 고객만족을 위해 최선을 다합니다.

정 직
화인사이언스는 고객의 연구 개발에 진정한 동반자로 함께 할 것을 약속드립니다.
창 의
화인사이언스는 미래 신성장 사업기반의 창의를 통해 지속적으로 앞으로 나아가겠습니다.
회사명 (주)화인사이언스
주소 서울특별시 구로구 구로중앙로 207(구로동) 오퍼스1, 1동 307~308호
사업자 등록번호 336-86-01902
대표 고정민
전화 02-2636-8242
팩스 02-2636-8244
통신판매업신고번호 제 2021-서울구로-1854 호
개인정보 보호책임자 고정민
부가통신사업신고번호 12345호